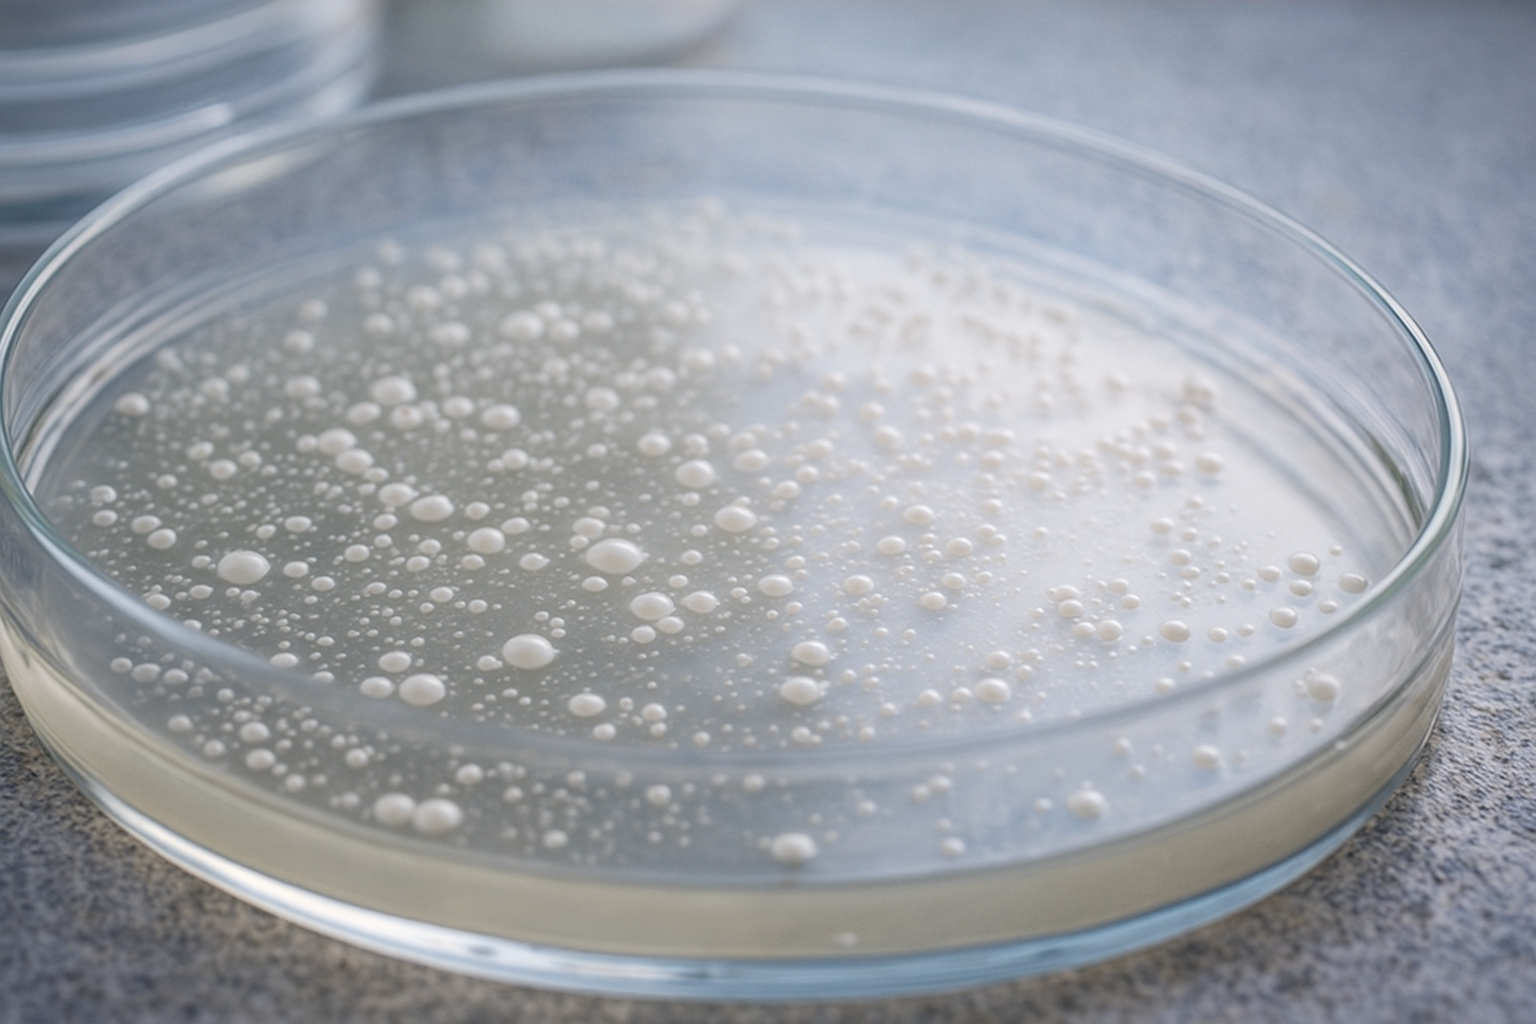

🧫 基礎情報:産業・研究用酵母
- 分類:多くは Saccharomyces cerevisiae(モデル生物)
- 用途:遺伝子工学/医薬品生産/酵素生産/バイオ燃料/食品産業
- 特徴:遺伝子改変が容易/代謝経路の制御がしやすい/大量培養に適する
- 環境耐性:温度・pH・高浸透圧への耐性を持つ工業株も存在
- 代表株:S288C、BYシリーズ、工業用高発酵株など
- 備考:人類の科学・産業の基盤を支える“微生物モデル”の代表。
― 酵母は食品だけの存在ではない。 その細胞の中には、医薬品や酵素、バイオ燃料を生み出すための“工場”としての能力が備わっている。 特にSaccharomyces cerevisiaeは、生命科学のモデル生物として世界中の研究者に利用され、 同時に産業の現場でも大規模発酵の主役を担ってきた。
酵母は遺伝子改変がしやすく、代謝経路を自在に調整できる。 そのため、ビタミンや医薬品の前駆体、香料、さらにはバイオ燃料まで、 多様な物質生産に応用されている。 人が作りたい“分子”を生産する小さな生物工場──それが産業酵母だ。
ここでは、研究用酵母の特徴、工業的発酵の仕組み、遺伝子工学による改変、 そして未来のバイオ産業における酵母の可能性を見ていく。
🧫目次
- 🧬 1. 研究用モデル生物 ― S. cerevisiae の強み
- 🏭 2. 工業発酵 ― 酵素・医薬品・燃料生産の現場
- 🧪 3. 遺伝子工学による改変 ― 代謝をデザインする
- 🚀 4. 未来のバイオ産業 ― 酵母が拓く可能性
- 🌙 詩的一行
🧬 1. 研究用モデル生物 ― S. cerevisiae の強み
研究用酵母の主役は、言わずと知れた Saccharomyces cerevisiae。 この酵母は生命科学において、ヒト細胞の仕組みを理解するための“縮図”として扱われている。
- 遺伝子の扱いやすさ:ゲノム編集・組換えが容易
- 世代時間が短い:短期間で進化・変異の観察が可能
- ヒトに近い性質:多くの遺伝子がヒトと相同
- 大量培養が簡単:研究室での扱いやすさが抜群
ノーベル賞級の発見の多くが、酵母研究から生まれている。
🏭 2. 工業発酵 ― 酵素・医薬品・燃料生産の現場
工業酵母は、食品以外の世界で活躍する“生産者”だ。
- 酵素生産:製パン用酵素・洗剤用酵素などの大量生産
- 医薬品:ビタミン・ステロイド前駆体・薬用酵素の生産
- 香料:バニリンなど香り成分の生合成
- バイオ燃料:エタノール・バイオブタノール生産
条件管理(温度・pH・酸素)を最適化することで、 酵母は“工場”として効率よく目的物質を生み出す。
🧪 3. 遺伝子工学による改変 ― 代謝をデザインする
酵母の魅力のひとつは、代謝経路を細かく“設計”できることだ。
- 遺伝子組換え:香り成分・医薬品原料を生産
- ゲノム編集:CRISPRで精密な改変が可能
- 代謝工学:糖 → 目的物質へ最適ルートを構築
- 耐性付与:低pH・高温・高浸透圧でも働く株を作る
こうして酵母は「生物工場」として磨かれ続けている。
🚀 4. 未来のバイオ産業 ― 酵母が拓く可能性
酵母は、未来の産業においてさらに重要な役割を担うと考えられている。
- 持続可能な化学品生産:石油に依らない発酵プロセス
- 食品開発:植物肉・発酵風味の基盤作り
- 医療分野:特定タンパク質の低コスト大量生産
- グリーンエネルギー:高効率エタノール生産株の開発
小さな細胞が、化学産業・医療・エネルギーの未来をひらく—— 酵母はそんな“次世代の鍵”を握っている。
🌙 詩的一行
ひとつの細胞が、未来の分子を静かに形にしていく。
🧫→ 次の記事へ(酵母13:発酵の科学)
🧫→ 酵母シリーズ一覧へ
コメント